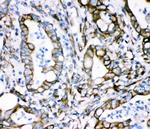
Plectin Antibody in Immunohistochemistry (Paraffin) (IHC (P))

Search
Invitrogen
Plectin Polyclonal Antibody
{{$productOrderCtrl.translations['antibody.pdp.commerceCard.promotion.promotions']}}
{{$productOrderCtrl.translations['antibody.pdp.commerceCard.promotion.viewpromo']}}
{{$productOrderCtrl.translations['antibody.pdp.commerceCard.promotion.promocode']}}: {{promo.promoCode}} {{promo.promoTitle}} {{promo.promoDescription}}. {{$productOrderCtrl.translations['antibody.pdp.commerceCard.promotion.learnmore']}}
图: 1 / 6
Plectin Antibody (PA5-79829) in ICC/IF

Please note: We are reviewing Western blot images included in the antibody testing data in our catalog, including those provided by third parties. Unless expressly labeled or annotated as “raw-unedited”, Western blot images included in the antibody testing data in our catalog may have been edited, optimized or otherwise adjusted for presentation.
产品信息
PA5-79829
种属反应
已发表种属
宿主/亚型
分类
类型
抗原
偶联物
形式
浓度
规格
纯化类型
保存液
内含物
保存条件
运输条件
RRID
产品详细信息
Reconstitute with 0.2 mL of distilled water to yield a concentration of 500 µg/mL.
Positive Control - WB: human Hela whole cell. IHC: human intestine cancer tissue, human lung cancer tissue, mouse intestine tissue, rat intestine tissue. ICC/IF: U20S cell.
靶标信息
Plectin is a prominent member of an important family of structurally and in part functionally related proteins, termed plakins or cytolinkers, that are capable of interlinking different elements of the cytoskeleton. Plakins, with their multi-domain structure and enormous size, not only play crucial roles in maintaining cell and tissue integrity and orchestrating dynamic changes in cytoarchitecture and cell shape, but also serve as scaffolding platforms for the assembly, positioning, and regulation of signaling complexes. Plectin is expressed as several protein isoforms in a wide range of cell types and tissues from a single gene located on chromosome 8 in humans. The expression of specific plectin isoforms was found to be dependent on cell type (tissue) and stage of development and it appears that each cell type (tissue) contains a unique set (proportion and composition) of plectin isoforms which carry out distinct and specific functions.
仅用于科研。不用于诊断过程。未经明确授权不得转售。
生物信息学
蛋白别名: HD1; Hemidesmosomal protein 1; PCN; Plectin; plectin 1; Plectin-1; Plectin-6
基因别名: AA591047; AU042537; EBS1; PCN; PLEC; PLEC1; PLTN
UniProt ID: (Mouse) Q9QXS1
Entrez Gene ID: (Rat) 64204, (Mouse) 18810




